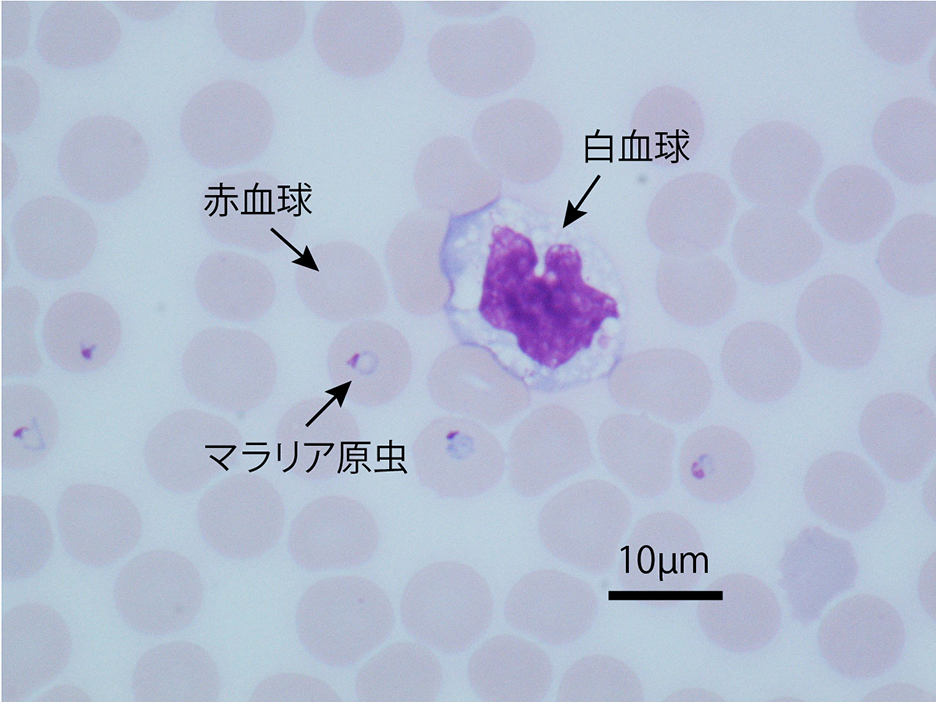

マラリアは、エイズや結核とともに世界三大感染症のひとつ。アフリカやアジア、中南米などの熱帯・亜熱帯地域を中心に、年間で2億人以上の人々が感染し、40万人以上が命を落としています。長崎大学 熱帯医学研究所の原虫学分野では、マラリア感染のメカニズム解明に、ニコンの顕微鏡を役立てています。
人類の大きな課題、それがマラリア。
マラリアは、1898年にイギリス人医学者、ロナルド・ロスが顕微鏡観察によって蚊の体内にマラリア原虫を発見し、原虫を持った蚊に刺されることで感染することを証明するまで、空気感染する病気と思われていました。
人のマラリアはハマダラカによって媒介されます。感染すると1週間から4週間程の潜伏期間後に発症し、初期症状として高熱が出ます。さらに進行すると、意識障害、腎障害、肺水腫、重症貧血、多臓器不全といった症状が起こり、最悪の場合は死に至ります。抵抗力の弱い、乳幼児、妊娠中の人、高齢者は特に注意が必要です。

※実験用で原虫は持っていません。
画像ご提供:
長崎大学熱帯医学研究所 二見恭子先生

マラリアの流行地域は、アフリカ、アジア、中南米などの熱帯・亜熱帯が中心。近年では毎年2億人以上が感染し、40万人以上の人が命を落としています。マラリアはかつてヨーロッパや北米などでも流行していましたが、上下水道の整備や、公衆衛生の向上、殺虫剤や特効薬の利用などにより撲滅されています。日本も1950年代に撲滅に成功。しかし、海外で感染した旅行者が帰国・入国後に発症するというリスクはいまだに残されています。多くの人々が世界中を行き来する時代。マラリアは流行地域での対策はもちろん、国際的な取り組みが必要な喫緊の課題となっているのです。
これまで、殺虫剤によるハマダラカ対策と殺虫剤塗布した蚊帳の使用や特効薬の処方により、マラリア感染者は2015年までは大きく減少していました。しかしここ数年は横ばい状態で、革新的な予防法や治療法、蚊への対策法などが出てこない限り、さらに大きく感染者を減らすことは難しい状況です。いま、世界中の製薬会社や最先端の研究施設で、ワクチンや予防薬、治療薬、診断法などの開発が進められています。
マラリアを始めとする熱帯病に取り組む、
NEKKEN=熱帯医学研究所。
マラリア研究の日本における重要拠点のひとつが、長崎大学 熱帯医学研究所(NEKKEN)の原虫学分野です。熱帯医学研究所は、1942(昭和17)年に設立された東亜風土病研究所を前身とし、熱帯病の撲滅・制御にむけた研究に取り組んでいます。現在、その活動は多岐にわたり、エボラ出血熱、ジカ熱、マラリアなどの克服に貢献しています。また、約50年前からアフリカのケニアとの協力関係を継続。また、ケニアを始めその他のアフリカ諸国、アジア、中南米各国の研究者や研修生、学生を研究所へ受け入れています。


今回お話しを伺ったのは、原虫学分野の責任者である金子修教授。1992(平成4)年から27年間、マラリアに取り組み続けてこられました。
金子先生の分野の主なテーマは、マラリア原虫についての基礎的な情報を徹底して集めること。そのためのさまざまな研究を行っています。「ざっくり言うとマラリア原虫が体のなかで増える仕組みを分子レベルで明らかにする研究です」とおっしゃっていました。
マラリア原虫ライフサイクルは実に複雑です。大きくは、人の肝細胞内の『赤外期』、赤血球の中の『赤内期』、ハマダラカの中の『蚊体内期』という三つのステージがあります。

原虫学分野 金子修教授

- 『赤外期』
- マラリア原虫を持ったハマダラカが人を刺すことで、蚊の唾液中に潜む “スポロゾイト”という形態の原虫が人体に注入されます。“スポロゾイト”は肝臓の細胞へ侵入して発育しますが、一部は休眠体となり数週間から数年後に活動を始めマラリア再発の要因となります。肝細胞内で発育した原虫は、数千個の“メロゾイト”に分裂した後、肝細胞を破壊し血流中に放出されます。
- 『赤内期』
- “メロゾイト”は次に赤血球に侵入します。そこで十数個前後に分裂した後、再び血流中に放出され、また新たな赤血球に侵入するというサイクルを繰り返します。さらに赤血球内の原虫はときおり雌雄の生殖母体に分化します。
- 『蚊体内期』
- 生殖母体は吸血によってハマダラカの体内へ移動。蚊の中腸内で有性生殖し、最終的に蚊の唾液に潜む“スポロゾイト”となります。(図と本文の説明では、蚊体内期の原虫の発育は省略)
このように、マラリア原虫のライフサイクルは、場所を変え、形態を変え、非常に複雑で巧妙。その詳細はまだまだ解明されていないところが多いのです。
マラリア感染のメカニズム解明に顕微鏡が貢献。
顕微鏡は1898年当時、マラリア原虫が蚊によって媒介されることの証明に不可欠なものでした。そして現在も、マラリアの感染メカニズムの解明に大きく貢献しています。
金子先生の研究室では、マラリア原虫の増殖を食い止める標的となる分子、つまりマラリア原虫の弱点を見出すために、原虫がどのように赤血球に侵入しているのかを調べています。
その過程は次のようなものです。まず、マラリア原虫の“メロゾイト”が赤血球に接触すると、赤血球を変形させながら赤血球膜との間に密着接合を形成します。続いて赤血球内部に寄生胞膜という新たな膜を形成しながら、その中に入ります。この過程では、マイクロネームやロプトリーといった小器官から、放出されるさまざまな分子が作用しています。赤血球は直径が10µm、厚さが2µmほどで肉眼では見られません。“メロゾイト”はさらに小さく1µmほどなので、顕微鏡は必須の機材となります。
マラリア原虫の巧みな侵入メカニズムには他にも多くの原虫分子が関わっていますが、その中にワクチンや薬剤開発の標的となる有望な分子が潜んでいます。だからこそ、顕微鏡によってマラリア原虫を見つめ続け、あらゆる情報を収集していくことが必要なのです。

長崎大学-ニコン 感染症イメージングコア・ラボラトリーにて
顕微鏡はさらに、原虫分子がマラリア原虫のどこに存在するのかの特定や、原虫が発育のために形態を変えたり、赤血球侵入を繰り返すきっかけとなる、リン酸化やカルシウムを介したシグナル伝達メカニズムの解明にも大きく貢献しています。
また、ケニアにある拠点を中心に行っている、現地でのマラリア感染状況の調査や、媒介蚊のフィールド調査・研究、そしてこれらの活動で収集したマラリア原虫の薬剤耐性の試験にも顕微鏡が大きく役立っています。

大阪市立大学大学院医学研究科 木村政継先生

大阪市立大学大学院医学研究科 加賀谷渉先生


「マラリア原虫の弱点を生物学的な関係性の中で理解できれば、ワクチンや薬剤、診断法の開発や改良に貢献できると考えています。さらに原虫の薬剤耐性の仕組みを明らかにして治療などに役立てることができればと願っています。私たちの研究がマラリアで苦しんでいる人々の健康や幸福につながればとても嬉しく思います。」
このように、金子教授は研究者としての熱い思いをインタビューの最後に述べられました。
研究者も含め、いま世界で多くの人々がマラリアと戦っています。ニコンの顕微鏡がその一助になれることを、私たちも願っています。
金子教授の他に今回のインタビューにご協力いただいたお二人

長崎大学 熱帯医学研究所 原虫学分野
矢幡一英 助教
<コメント>私の役割は、研究室のメンバー全員が一体となって研究を進められるようアドバイスをすることです。また、ケニアその他の国からの研究者、研修生、学生のサポートも行っています。

ケニアからの研修生
Edwin Tooさん
<コメント>私の国では、毎年多くの人がマラリアで亡くなります。特に小さな子供と、若い妊娠中の女性です。熱帯医学研究所でしっかりと学んで、これらの悲劇を少なくするために貢献したいです。

